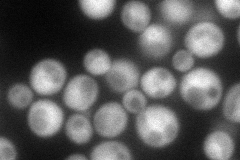
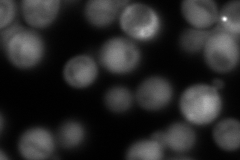

View description
One of two (see also PTH1) mitochondrially-localized peptidyl-tRNA hydrolases; negatively regulates the ubiquitin-proteasome pathway via interactions with ubiquitin-like ubiquitin-associated proteins; dispensable for cell growth
Localization:
Intensity:
Fold change:
Significance:
-
C’ GFP library in SD

below threshold17.43 -
N' NOP1pr-GFP in SD
cytosol,nucleus114.597 -
N' TEF2pr-mCherry in SD
cytosol231.061 -
N' NATIVEpr-GFP in SD

below threshold29.422 -
N' TEF2pr-VC and Cyto-VN in SD

#N/A0 -
C’ GFP library in SD+DTT

cytosol17.330.99No -
C’ GFP library in SD+H2O2

cytosol14.420.82No -
C’ GFP library in Starvation Media

cytosol21.581.23No -
C’ GFP library on the background of Pup2-DaMP

below threshold -
C’ GFP library on the background of CCT mutant

below threshold16.62320.952897No
